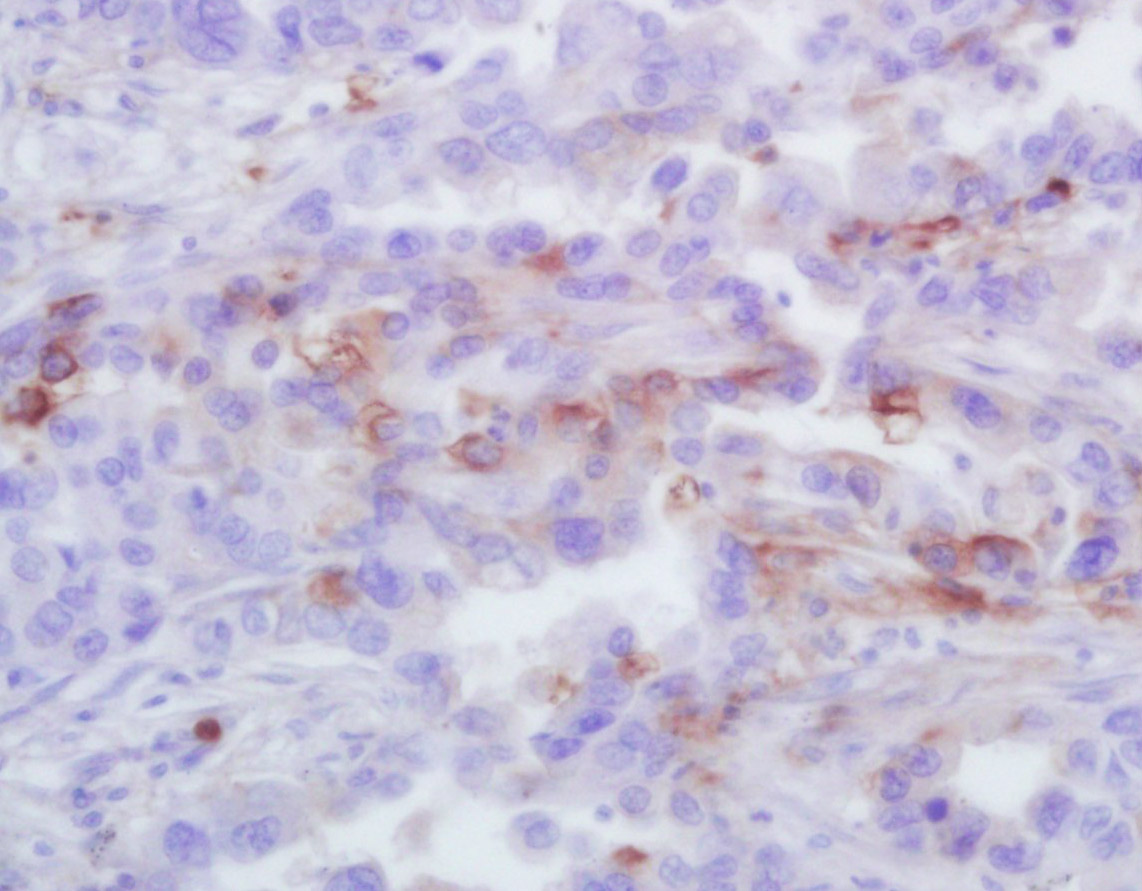
产品细节图片3

相关产品推荐更多 >
万千商家帮你免费找货
0 人在求购买到急需产品
- 详细信息
- 文献和实验
- 技术资料
- 应用范围:
产品信息以Bioss网站为准
- 规格:
50ul/100ul/200ul
| 规格: | 50ul | 产品价格: | ¥1180.0 |
|---|---|---|---|
| 规格: | 100ul | 产品价格: | ¥1980.0 |
| 规格: | 200ul | 产品价格: | ¥2800.0 |
| 产品编号 | bs-10234R |
| 英文名称 | GRO Alpha Rabbit pAb |
| 中文名称 | 黑色素瘤生长刺激活性蛋白α/GROa抗体 |
| 英文别名 | CINC1; GRO-1; CXCL1; C-X-C motif chemokine 1; CALC 1; CALCA; Calcitonin related polypeptide alpha; Catacalcin; CGRP I; CGRP1; CGRPI; Chemokine(C-X-C motif) ligand 1(melanoma growth stimulating activity, alpha); chemokine(C-X-C motif) ligand 1; Chemokine(C-X-C motif) ligand 2; CINC-1; Cxcl1; CXCL2; Cytokine-induced neutrophil chemoattractant 1; Fibroblast secretory protein; Fsp; Gro 1; Gro A; Gro; GRO protein, alpha; Gro1; GRO1 oncogene(melanoma growth stimulating activity, alpha); GRO1 oncogene(melanoma growth-stimulating activity); Gro1 oncogene; GROa; GROA_HUMAN; Growth regulated protein GRO; Growth regulated protein GRO; Growth-regulated alpha protein; Katacalcin; KC; KC chemokine, mouse, homolog of; melanoma growth stimulatory activity alpha; Melanoma growth stimulatory activity; Melanoma growth stimulatory activity, alpha; MGC126648; MGSA alpha; MGSA; MGSA-a; N51; NAP-3; NAP3; Neutrophil-activating protein 3; Platelet-derived growth factor-inducible protein KC; Platelet-derived growth factor-inducible protein KC; Scyb 1; Scyb1; Secretory protein N51; Secretory protein N51; Small inducible cytokine subfamily B, member 1. |
| 中文别名 | GROα; GRO α; GRO-α; |
| 产品应用 | IHC-P=1:100-500, IHC-F=1:100-500, IF=1:100-500 Not yet tested in other applications. |
| 交叉反应 | Human (Mouse, Rat) |
| 抗体来源 | Rabbit |
| 免疫原 | KLH conjugated synthetic peptide derived from mouse GRO Alpha |
| 亚型 | IgG |
| 性状 | Liquid |
| 纯化方法 | affinity purified by Protein A |
| 克隆类型 | Polyclonal |
| 理论分子量 | 7.8 kDa |
| 浓度 | 1mg/ml |
| 储存液 | 0.01M TBS (pH7.4) with 1% BSA, 0.02% Proclin300 and 50% Glycerol. |
| 研究领域 | Immunology > Innate Immunity > Chemokines > Alpha Chemokines (CXC) |
| 亚细胞定位 | Secreted. |
| 翻译后修饰 | N-terminal processed forms GRO-alpha(4-73), GRO-alpha(5-73) and GRO-alpha(6-73) are produced by proteolytic cleavage after secretion from peripheral blood monocytes. |
| 相似性 | Belongs to the intercrine alpha (chemokine CxC) family. |
| 功能 | Has chemotactic activity for neutrophils. May play a role in inflammation and exerts its effects on endothelial cells in an autocrine fashion. In vitro, the processed forms GRO-alpha(4-73), GRO-alpha(5-73) and GRO-alpha(6-73) show a 30-fold higher chemotactic activity. |
| 保存条件 | Shipped at 4℃. Store at -20℃ for one year. Avoid repeated freeze/thaw cycles. |
| 注意事项 | This product as supplied is intended for research use only, not for use in human, therapeutic or diagnostic applications. |
| 背景资料 | The GRO gene was originally identified by subtractive hybridization studies between normal and tumorigenic Chinese hamster embryo fibroblasts. The hamster cDNA was cloned and used as a probe for cloning of the human GRO cDNA. The GROalpha gene initially cloned from T24 cells and the gene in melanoma cells encoding melanoma growth stimulating protein (MGSA) are identical. Human cells contain three closely related, but distinct GRO genes: GRO alpha, GRO beta, and GRO gamma. GRO beta and GRO gamma share 93% and 82% identity, respectively, with GRO alpha at the nucleotide level. GROs are members of the chemokine alpha family that is characterized by the separation with one amino acid of the first two cysteine residues, C-X-C, in the amino acid sequence. The GRO gene has been mapped to chromosome 4q21. In normal cells, human mRNA GRO expression is found in foreskin fibroblasts, synovial fibroblasts, chondrocytes and osteocytes. Additionally, GRO mRNA has been detected in mammary fibroblasts, mammary epithelial cells, endothelial cells, activated monocytes, macrophages, and neutrophils. Characterization of the GROalpha receptor indicates the presence of low and high affinity receptors on human neutrophils. |
| 应用 | 推荐稀释比例 |
| {IHC-P} | {1:100-500} |
| {IHC-F} | {1:100-500} |
| {IF} | {1:100-500} |

Antigen retrieval: citrate buffer ( 0.01M, pH 6.0 ), Boiling bathing for 15min; Block endogenous peroxidase by 3% Hydrogen peroxide for 30min; Blocking buffer (normal goat serum,C-0005) at 37℃ for 20 min;
Incubation: Anti-GRO Alpha Polyclonal Antibody, Unconjugated(bs-10234R) 1:200, overnight at 4°C, followed by conjugation to the secondary antibody(SP-0023) and DAB(C-0010) staining
风险提示:丁香通仅作为第三方平台,为商家信息发布提供平台空间。用户咨询产品时请注意保护个人信息及财产安全,合理判断,谨慎选购商品,商家和用户对交易行为负责。对于医疗器械类产品,请先查证核实企业经营资质和医疗器械产品注册证情况。
文献和实验[IF={{ 5.996 }}] {Rossella Di Sapia. et al. CXCL1-CXCR1/2 signaling is induced in human temporal lobe epilepsy and contributes to seizures in a murine model of acquired epilepsy. Neurobiol Dis. 2021 Oct;158:105468} {IHC} {Mouse}
[IF={{ 4.4 }}] {Dohi Akihiro. et al. Acute stress transiently activates macrophages and chemokines in cervical lymph nodes. IMMUNOL RES. 2024 Feb;:1-13} {IHC} {Rat}
[IF={{ 4.249 }}] {Zhou L et al. Levo-corydalmine alleviates vincristine-induced neuropathic pain in mice by inhibiting an NF-kappa B-dependent CXCL1/CXCR2 signaling pathway. Neuropharmacology. 2018 Jun;135:34-47.} {IF} {Mouse}
[IF={{ 3.889 }}] {Tianrui Zhang. et al. Daphnetin alleviates neuropathic pain in chronic constrictive injury rats via regulating the NF-κB dependent CXCL1/CXCR2 signaling pathway. PHARM BIOL. 2023;61(1):746-754} {IF} {Rat}
[IF={{ 3.454 }}] {Odum James D.. et al. Candidate Biomarkers for Sepsis-Associated Acute Kidney Injury Mechanistic Studies. SHOCK. 2022 May;57(5):687-693} {IHC} {Mouse}
Nucleic Acid Programmable Protein Arrays: Versatile Tools for Array‐Based Functional Protein Studies
.g., Sigma) 50 mg/ml bis‐sulfosuccinimdylsuberate (BS3 ;Pierce, cat. no. PI 21580) in dimethylsulfoxide (DMSO) 5 mg/ml
Generation of Spatio‐Temporally Controlled Targeted Somatic Mutations in the Mouse
Syringe (1‐ml equipped with a 25‐G needle; Terumo, cat. no. BS‐01 H2516) Gas anesthesia station for rodents (TEM)
技术资料暂无技术资料 索取技术资料








